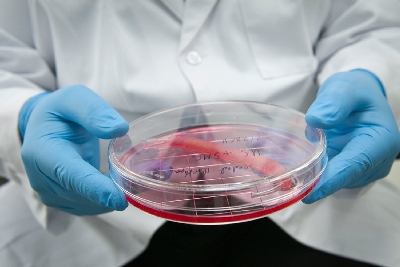

- Головна
- Здоров`я та технології
Вчені перевірили тест, що визначає 8 видів раку на ранній стадії
Вівторок, 23 січня 2018 11:57 Вчені американського Університету Джона Хопкінса повідомили про тест крові, який виявляє багато видів раку на ранній стадії. У їх числі найбільш небезпечні, для яких зараз немає інструментів скринінгу.
Вчені американського Університету Джона Хопкінса повідомили про тест крові, який виявляє багато видів раку на ранній стадії. У їх числі найбільш небезпечні, для яких зараз немає інструментів скринінгу.
Вчені створили робот-імплантат для лікування стравоходу
Понеділок, 22 січня 2018 13:25 Група інженерів і клініцистів Інженерного факультету Університету Шеффілда, Бостонської дитячої лікарні Гарвардської медичної школи розробила м’який роботизований імплант для лікування рідкісного вродженого дефекту стравоходу.
Група інженерів і клініцистів Інженерного факультету Університету Шеффілда, Бостонської дитячої лікарні Гарвардської медичної школи розробила м’який роботизований імплант для лікування рідкісного вродженого дефекту стравоходу.
Дослідники виявили білок, який лікує рак і діабет
Понеділок, 22 січня 2018 13:12 Група дослідників з Єльського університету виявила протеїн, який бореться зі старінням. Це білок Клото, який може лікувати безліч захворювань, у тому числі діабет і рак.
Група дослідників з Єльського університету виявила протеїн, який бореться зі старінням. Це білок Клото, який може лікувати безліч захворювань, у тому числі діабет і рак.
Вчені розробили 3D друковані структури, схожі на тканини мозку і легенів
Четвер, 18 січня 2018 11:43 Британські учені з Імперського коледжу Лондона розробили спосіб тривимірного друку м'яких біологічних структур, які можуть бути використані для створення життєвих моделей мозку і легенів.
Британські учені з Імперського коледжу Лондона розробили спосіб тривимірного друку м'яких біологічних структур, які можуть бути використані для створення життєвих моделей мозку і легенів.
Вчені використали патч з серцевих клітин для пом’якшення інфаркту
Середа, 17 січня 2018 12:44 Вчені Університету Алабами та Бірмінгемської біомедичної інженерії, спільно з відділенням Медичної школи та Школи інженерних наук провели дослідження, яке передбачає покращення відновлення після серцевого нападу.
Вчені Університету Алабами та Бірмінгемської біомедичної інженерії, спільно з відділенням Медичної школи та Школи інженерних наук провели дослідження, яке передбачає покращення відновлення після серцевого нападу.
Вчені відповіли, чому люди з ожирінням важко скидають вагу
Середа, 17 січня 2018 12:16 Дослідники з Університету Ексетера виявили причину, по якій люди, що страждають ожирінням, з труднощами втрачають зайву вагу.
Дослідники з Університету Ексетера виявили причину, по якій люди, що страждають ожирінням, з труднощами втрачають зайву вагу.
Біоінженери перетворили клітини шкіри у м’язи
Понеділок, 15 січня 2018 12:24 Біомедичні інженери створили першу функціонуючий м'яз з індукованих плюрипотентних стовбурових клітин шкіри.
Біомедичні інженери створили першу функціонуючий м'яз з індукованих плюрипотентних стовбурових клітин шкіри.
Винайдений скін-патч, який допомагає зменшити ожиріння
Понеділок, 08 січня 2018 12:42 Вчені Сінгапурського Технологічного університету в Наньяні розробили новий тип скін-патча (трансдермальний пластир), який допомагає зменшити кількість жиру в тілі.
Вчені Сінгапурського Технологічного університету в Наньяні розробили новий тип скін-патча (трансдермальний пластир), який допомагає зменшити кількість жиру в тілі.
Вчені виявили новий білок, що допомагає імунній системі боротися з раком
П'ятниця, 29 грудня 2017 12:25 Вчені Імперського коледжу Лондона виявили білок, який підсилює імунну систему для боротьби з будь-яким видом раку або вірусу.
Вчені Імперського коледжу Лондона виявили білок, який підсилює імунну систему для боротьби з будь-яким видом раку або вірусу.
У США народилася дитина з ембріона, на рік молодшого за його матір
Понеділок, 25 грудня 2017 12:32 Американка Тіна Гібсон народила дівчинку Емму з ембріона, замороженого в 1992 році. Це був найстарший ембріон, використаний для ЕКО.
Американка Тіна Гібсон народила дівчинку Емму з ембріона, замороженого в 1992 році. Це був найстарший ембріон, використаний для ЕКО.




